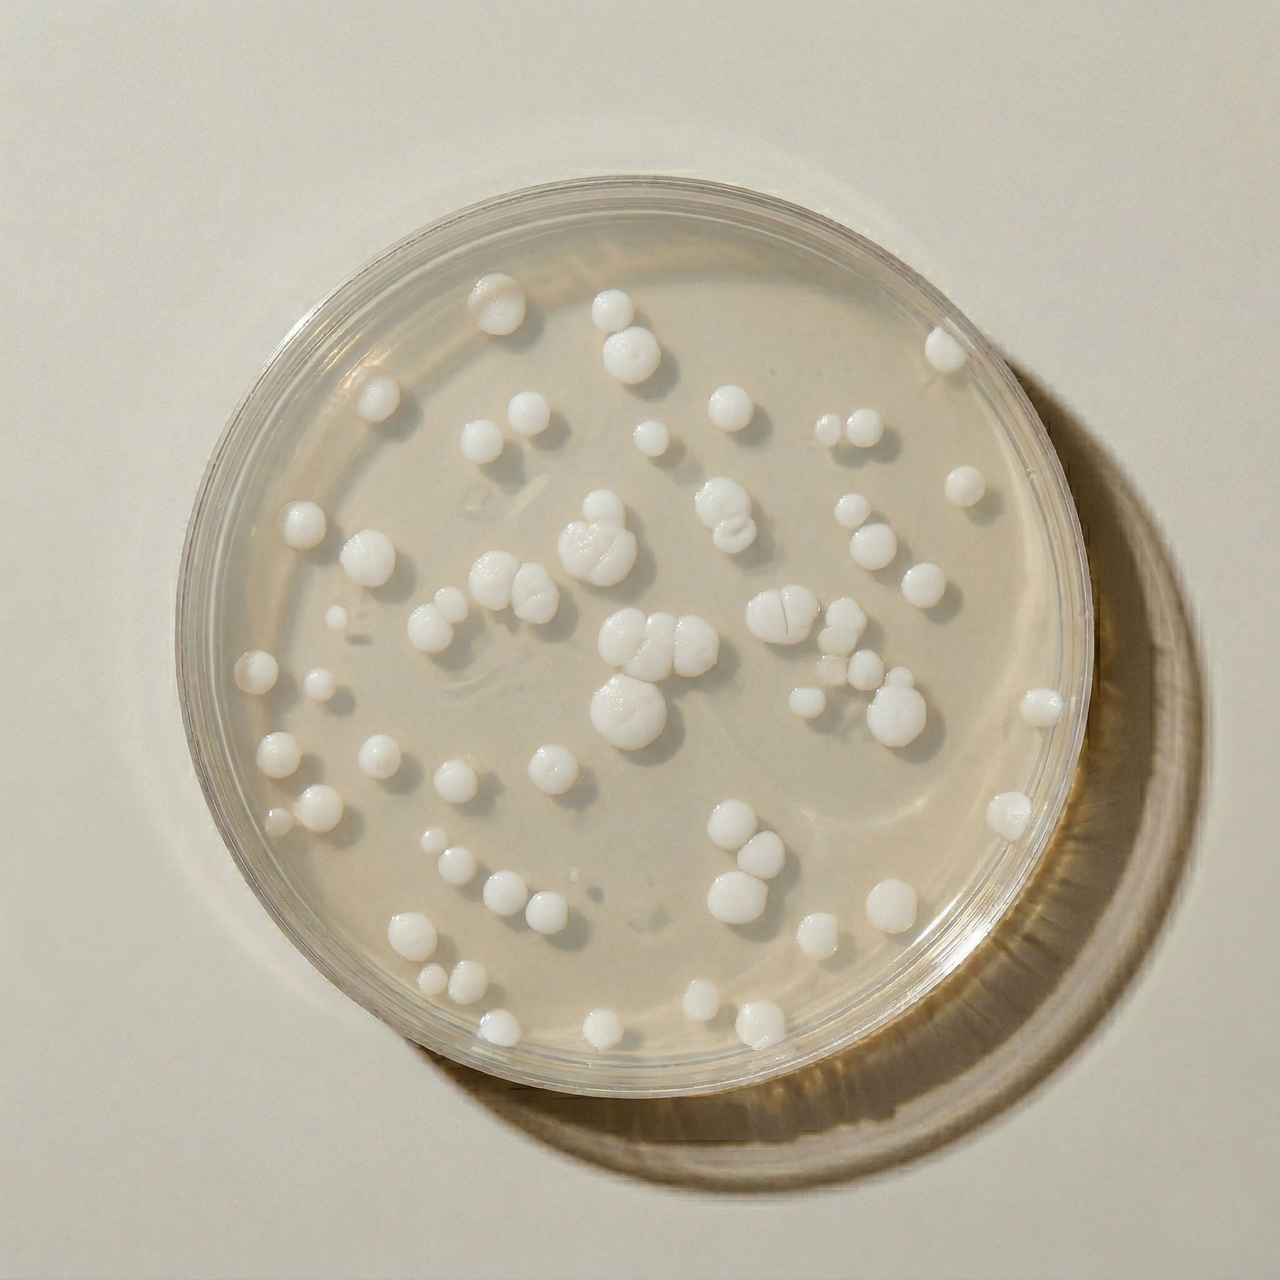
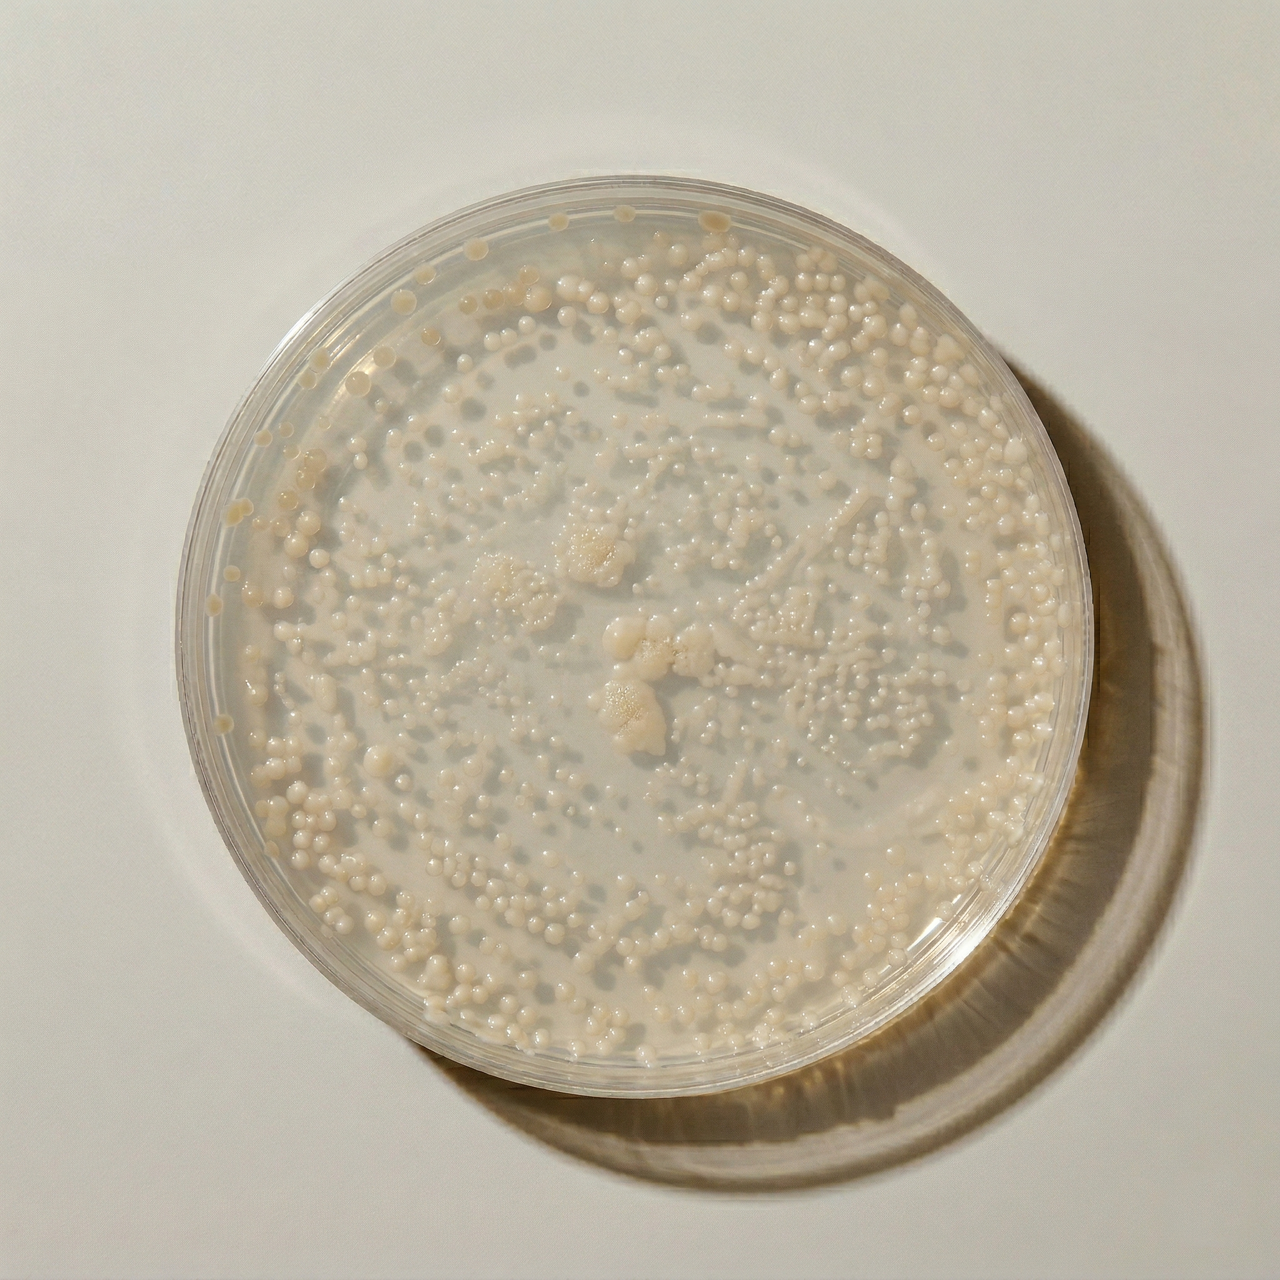

SALUD QUE SE CONSTRUYE DIA A DIA
empieza:
2026
Cuidarles bien no es reaccionar. Es anticiparse.
empieza ya
H
:
M
:
S
EL HÁBITO QUE PROTEGE SU FUTURO
Suplemento diario que contribuye a:
Metabolismo y vitalidad
Salud cognitiva y cerebral
Salud cardiovascular
Sistema inmunitario
Articulaciones y movilidad
Piel y pelaje
Digestión y microbiota
Salud ocular
Protección antioxidante

Nuestros ingredientes
VER TODOS AQUI
Mas de 30 beneficios demostrados científicamente en perros y gatos
Equilibrio inmunitario
Salud a largo plazo
Metabolismo energético
Rendimiento neurológico
Salud ocular
Protección celular
Mantenimiento de piel y pelaje
Articulaciones y mobilidad
Bienestar digfestivo
Salud cardiovascular

Todo en una sola vez
Pawer está diseñado para que no tengas que preocuparte sobre la suplementación de tu mascota.
Es la mejor forma de invertir en su vida a largo plazo.
pawer contains your


pawer contiene
– Multivitaminicos
– Multimineral
– Gut-Friendly Bacteria
– Gut-Friendly Fibre
– Antioxidants
– Great Ingredients
– Quality Mushrooms
¿Qué nos hace especiales?
Fórmula real, por personas reales
Este proyecto no nació en una gran multinacional.
Nació de personas que aman a sus perros y querían la tranquilidad de saber que no les falta
nada.
Impacto visible
No buscamos que “parezca que funciona”.
Buscamos que lo notes: en cómo se mueve, en cómo digiere, en cómo disfruta.
Complejidad bien dise�ñada
No es un ingrediente milagro.
Una formulación sin rellenos ni tonterías, una combinación precisa de compuestos que
trabajan juntos donde tu perro lo necesita.
Fácil para ti, mejor para él
Nada de complicaciones.
Un hábito sencillo que te deja tranquilo, porque sabes que le has dado a tu perro todo lo que
necesita.
Descubre una suplementación a medida, pensada semana a semana
CUANTO NECESITAS?
La rutina más sencilla



"Un perro no es tu vida entera, pero cambia tu forma de vivirla"
— James Herriot
Preguntas comunes
¿Sigues sin respuestas? Pregunta a nuestro equipo mas abajo.
PawerOne está pensado para prácticamente todos los perros a partir de los 6 meses, independientemente de la raza o el tamaño. Es un suplemento de uso diario enfocado en el cuidado general, no en una situación puntual.
Se puede utilizar tanto en perros que están perfectamente, como forma de prevención, como en perros que ya necesitan un apoyo extra en digestión, movilidad, energía o bienestar general.
Si tu perro tiene alguna condición concreta de salud o está bajo tratamiento, en ese caso sí es recomendable confirmarlo previamente con tu veterinario.
La principal diferencia es el enfoque.
Muchos suplementos se centran en una sola función, como articulaciones o digestión. PawerOne está diseñado como una fórmula completa que trabaja varias áreas clave al mismo tiempo: microbiota, digestión, articulaciones, energía, piel, pelaje, sistema inmune y protección antioxidante.
Además, no se basa en un ingrediente protagonista, sino en una combinación bien estructurada de compuestos que actúan de forma complementaria.
Y, sobre todo, está pensado para la vida real: una sola toma al día, fácil de incorporar a la rutina y sin necesidad de combinar varios productos distintos.
Lo habitual es empezar a notar cambios a las pocas semanas de uso continuado.
En algunos casos, especialmente a nivel digestivo o de energía, puede haber mejoras antes. Pero en general, al tratarse de un suplemento de uso diario, el efecto es progresivo y acumulativo.
La clave está en la constancia, más que en buscar un efecto inmediato.
Porque es la forma más cómoda y también la más ventajosa de usar PawerOne.
Al tratarse de un suplemento diario, lo importante es mantener la continuidad. La suscripción te permite recibir el producto justo cuando lo necesitas, según el consumo de tu perro, sin tener que estar pendiente de reponerlo.
Además, al suscribirte puedes obtener el producto a un mejor precio, y verás el descuento disponible directamente al añadirlo a la cesta.
Es la opción que eligen la mayoría de clientes que lo incorporan como rutina diaria.
Actualmente puedes pagar con tarjetas de crédito y débito (Visa, Mastercard, American Express), así como mediante Apple Pay, Google Pay, Klarna, PayPal, Shop Pay y UnionPay.
En este momento realizamos envíos a España y Portugal.
El plazo habitual de entrega es de entre 3 y 5 días laborables y el envío es gratuito.
¿Tienes otra pregunta?
No dudes en contactar con nuestro equipo a través del siguiente siguiente e-mail: contact@pawercare.com